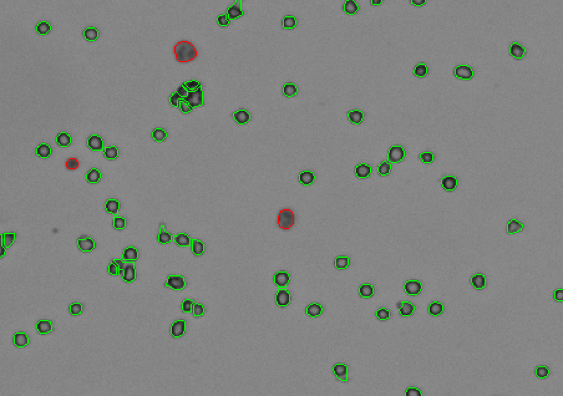

Cellaca™ MX

Automatyczne liczniki komórek
Cellaca MX wysokoprzepustowy, automatyczny fluorescencyjny licznik komórek:
- Pomiar liczby i żywotności komórek w jasnym polu (z użyciem Błękitu Trypanu): 24 próbki w 48 s.
- Pomiar żywotności z wykorzystaniem barwników fluorescencyjnych: 24 próbki w 2.5min
- Oprogramowanie pozwalające na liczenie i określanie żywotności komórek, stężenia komórek, średnicy komórek
- Aplikacje komórkowe:
- Apoptoza
- Potencjał błony mitochondrialnej
- Ekspresja białek (GFP, RFP)
- Reaktywne formy tlenu (ROS)
Zalety:
- Pomiar do 24 próbek w jednym cyklu
- Mała objętość próbki: 25mikrolitrów
- Szybki autofokus
- Dwukolorowe obrazowanie fluorescencyjne (MX FL2) możliwość obrazowania 2 z 5 fluorescencji (MX FL5)
- W trybie fluorescencji zliczanie tylko komórek jądrzastych (brak konieczności lizy erytrocytów dla preparatów z krwi)
- Przeznaczony do analiz złożonych próbek takich jak krew pełna, krew obwodowa, krew pępowinowa, szpik kostny
- Predefiniowane protokoły
- Zgodności z 21 CFR Part 11
- Pomiar liczby i żywotności komórek w jasnym polu (z użyciem Błękitu Trypanu): 24 próbki w 48 s.
- Pomiar żywotności z wykorzystaniem barwników fluorescencyjnych: 24 próbki w 2.5min
- Oprogramowanie pozwalające na liczenie i określanie żywotności komórek, stężenia komórek, średnicy komórek
- Aplikacje komórkowe:
- Apoptoza
- Potencjał błony mitochondrialnej
- Ekspresja białek (GFP, RFP)
- Reaktywne formy tlenu (ROS)
Zalety:
- Pomiar do 24 próbek w jednym cyklu
- Mała objętość próbki: 25mikrolitrów
- Szybki autofokus
- Dwukolorowe obrazowanie fluorescencyjne (MX FL2) możliwość obrazowania 2 z 5 fluorescencji (MX FL5)
- W trybie fluorescencji zliczanie tylko komórek jądrzastych (brak konieczności lizy erytrocytów dla preparatów z krwi)
- Przeznaczony do analiz złożonych próbek takich jak krew pełna, krew obwodowa, krew pępowinowa, szpik kostny
- Predefiniowane protokoły
- Zgodności z 21 CFR Part 11
Opis
Cellaca MX wysokoprzepustowy, automatyczny fluorescencyjny licznik komórek:
Wysokoprzepustowy system pozwalający na analizę do 24 próbek w jednym cyklu w czasie poniżej 3 minut (dla pomiaru fluorescencyjengo). Wszystkie próbki umieszczone są na dedykowanej płytce pomiarowej
Umożliwia obrazowanie i analizę komórek w jasnym polu oraz w dwu kanałach fluorescencji. Model MX FL5 pozwala na wybór 2 z pośród 5 kanałów fluorescencji. Cellaca MX przeznaczony jest do definiowania liczby komórek, ich stężenia i żywotności, a także do bardziej zaawansowanych analiz, takich jak: apoptoza, , wydajność transfekcji, analiza markerów powierzchniowych itp.
Dane techniczne
Zakres pomiarowy:
Komórki 5-80 mikronów; 105 – 107 komórek/ml
Metoda pomiarowa:
Jasne pole/fluorescencja
Dostępne filtry fluorescencyjne:
Cellaca MX FL2 Wzbudzenia (LED): 470, 527nm Emisja (Filtry): 534, 655nm
Cellaca MX FL5 Wzbudzenia (LED): 365nm, 470nm, 527nm, 620nm Emisja (filtry): 452, 534, 605, 655, 692nm
Szybkość liczenia 24 próbek:
Błekit trypanu: 48s; 2 kanały fluorescencji: 2.5min
Wymiary (Szer. x gł. x wys.):
33cm x 33cm x 41cm
Dokumentacja do pobrania
Interaktywna broszura
PobierzCellaca™ MX
Automatyczne liczniki komórek
Brochure Cellaca MX 2.0 with 21 CFR EN
Pobierz
CellacaMX HT cell counter BF brochure EN
Pobierz